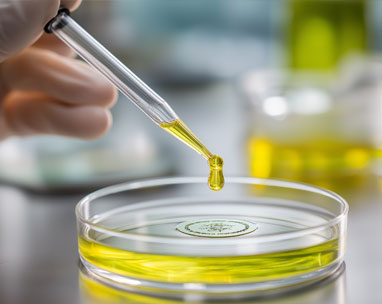

Titer up to ~39 g/L.
 中文
中文

Next-Generation

Upgraded Formula

30% Enhancement VS Competitors

Serum-Free

Chemically Defined

Perfectly Compatible with Canton's Self-Developed CHOZen® Cells and CANVector® Systems

Cell Growth

CHO Rise® Medium demonstrates excellent expression levels across multiple modalities

Glycosylation Analysis

Product Purity

Charge Variants








| Name | Catalog Number | Type | Specification |
| CHO-Rise @ BM01 (Basal Medium) | CB-MCBO1L-1L | Liquid | 1L |
| CB-MCB01P-1kg | Powder | 10L/50L | |
| CHO-Rise R BM02 (Basal Medium) | CB-MCB02L-1L | Liquid | 1L |
| CB-MCB02P-1kg | Powder | 10L/50L | |
| CHO-Rise R FM01 (Main Feed) | CB-MCFO1L-0.5L | Liquid | 0.5L |
| CB-MCF01P-1kg | Powder | 5L/50L | |
| CHO-Rise R FM02 (Main Feed) | CB-MCFO2L-0.5L | Liquid | 0.5L |
| CB-MCF02P-1kg | Powder | 5L/50L | |
| CHO-Rise @ FS01 (Supplemental Feed) | CB-MCS01L-0.2L | Liquid | 0.2L |
| CB-MCS01P-0.2kg | Powder | 1L/10L |
 Competitive Development Timeline
Competitive Development Timeline Diversified Chromatography Process Platform
Diversified Chromatography Process Platform Advanced Purification Processes
Advanced Purification ProcessesPurity > 98%
HCP residual < 20 ppm
Recovery rate ~80%
Purity > 98%
HCP
residual < 20ppm
Recovery rate ~ 80%
Purity > 98%
HCP residual < 50ppm
Recovery rate ~70%
Purity > 99%
HCP residual < 10ppm
Recovery rate ~70%
Purity > 98%
Host cell protein
residual < 100ppm
Recovery rate ~55%
Purity > 97%
HCP residual < 30ppm
Recovery rate ~60%
Purity > 97%
HCP residual < 50ppm
Recovery rate ~50%
Purity > 97%
HCP residual < 30ppm
Recovery rate ~60%